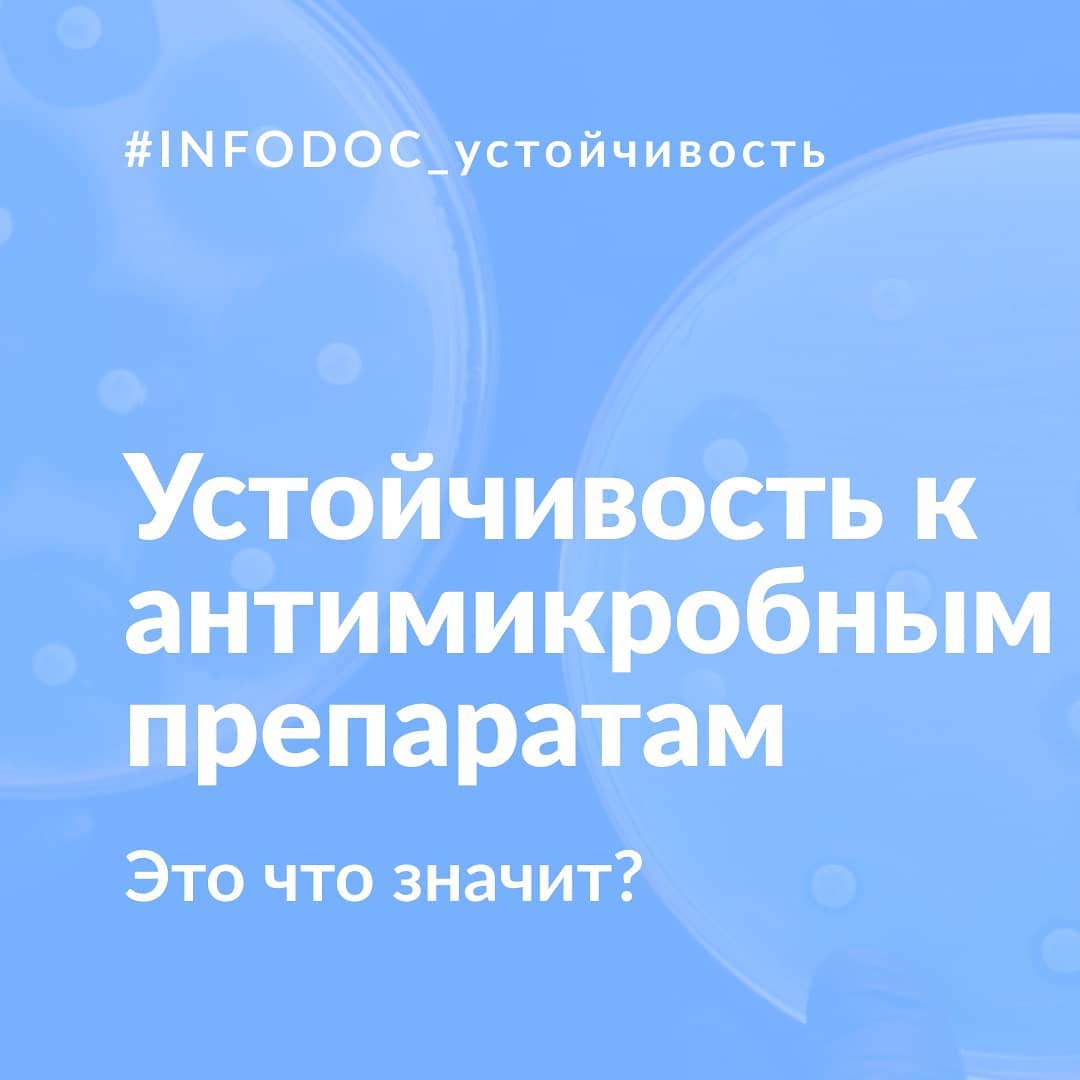

Б
Size: a a a
2020 October 25
Здравствуйте,соседи.Супруга(42л) заболела, температура и жжение в бронхах, металлический привкус и тд. Мы, с детьми вроде норм, но стал замечать заложенность на утро.полоскаем хлоргексидином, витамины C, D, амексин. Думаю для себя при этих первых симптомах сразу начать АЗИТРОМИЦИН.считаю, Легче победить вначале
R
Бор
Здравствуйте,соседи.Супруга(42л) заболела, температура и жжение в бронхах, металлический привкус и тд. Мы, с детьми вроде норм, но стал замечать заложенность на утро.полоскаем хлоргексидином, витамины C, D, амексин. Думаю для себя при этих первых симптомах сразу начать АЗИТРОМИЦИН.считаю, Легче победить вначале
#неврач
А что вы хотите победить?
В вашей семье, вероятнее всего вирус. ВИРУС АНТИБИОТИКАМИ НЕ ПОБЕДИТЬ.
И более того, его ничем не победить. Он сам по себе потерпит поражение-дело времени и интенсивности проветривания, увлажнения воздуха, обильного питья, рационального приема жаропонижающих.
Приемом антибиотиком вы окажете медвежью услугу себе и вообще всей популяции. Антибиотикорезистентность , слышали о таком?
https://www.instagram.com/p/CFb8lQkJXl8/?igshid=1l6c6zf7rwrcj
А что вы хотите победить?
В вашей семье, вероятнее всего вирус. ВИРУС АНТИБИОТИКАМИ НЕ ПОБЕДИТЬ.
И более того, его ничем не победить. Он сам по себе потерпит поражение-дело времени и интенсивности проветривания, увлажнения воздуха, обильного питья, рационального приема жаропонижающих.
Приемом антибиотиком вы окажете медвежью услугу себе и вообще всей популяции. Антибиотикорезистентность , слышали о таком?
https://www.instagram.com/p/CFb8lQkJXl8/?igshid=1l6c6zf7rwrcj
Б
Rimylka
#неврач
А что вы хотите победить?
В вашей семье, вероятнее всего вирус. ВИРУС АНТИБИОТИКАМИ НЕ ПОБЕДИТЬ.
И более того, его ничем не победить. Он сам по себе потерпит поражение-дело времени и интенсивности проветривания, увлажнения воздуха, обильного питья, рационального приема жаропонижающих.
Приемом антибиотиком вы окажете медвежью услугу себе и вообще всей популяции. Антибиотикорезистентность , слышали о таком?
https://www.instagram.com/p/CFb8lQkJXl8/?igshid=1l6c6zf7rwrcj
А что вы хотите победить?
В вашей семье, вероятнее всего вирус. ВИРУС АНТИБИОТИКАМИ НЕ ПОБЕДИТЬ.
И более того, его ничем не победить. Он сам по себе потерпит поражение-дело времени и интенсивности проветривания, увлажнения воздуха, обильного питья, рационального приема жаропонижающих.
Приемом антибиотиком вы окажете медвежью услугу себе и вообще всей популяции. Антибиотикорезистентность , слышали о таком?
https://www.instagram.com/p/CFb8lQkJXl8/?igshid=1l6c6zf7rwrcj
Спасибо
КП
КП
От пульмонолога Неешпапы)
П. С.: извиняюсь, если фамилия все же не склоняется
П. С.: извиняюсь, если фамилия все же не склоняется
Б
Катя Павлова
Спасибо. Прочитал. Особенно понятно про ризистенстность. Сутки, виферон 3млн ректально, день был без температуры
П
Бор
Спасибо. Прочитал. Особенно понятно про ризистенстность. Сутки, виферон 3млн ректально, день был без температуры
#неврач. Виферон препарат с недоказанной эффективностью, как и все неиньекционные фероны
Б
Будем доказывать
LD
Ждём Вашу нобелевскую
КП
Бор
Будем доказывать
Фероны могут сыграть злую шутку при лечении того, что само может пройти.
Человек может болеть по 3,4 и 7 даже раз в год орви без осложнений, и это нормально. Каждый раз использовать недоказанное по эффективности вещество - деньги на ветер. Зачем лезть в иммунная систему? Вы же не знаете досконально состояние своего здоровья. Онкология и аутоиммунки «хорошо» стимулируются интерферонами
Человек может болеть по 3,4 и 7 даже раз в год орви без осложнений, и это нормально. Каждый раз использовать недоказанное по эффективности вещество - деньги на ветер. Зачем лезть в иммунная систему? Вы же не знаете досконально состояние своего здоровья. Онкология и аутоиммунки «хорошо» стимулируются интерферонами
Б
Катя Павлова
Фероны могут сыграть злую шутку при лечении того, что само может пройти.
Человек может болеть по 3,4 и 7 даже раз в год орви без осложнений, и это нормально. Каждый раз использовать недоказанное по эффективности вещество - деньги на ветер. Зачем лезть в иммунная систему? Вы же не знаете досконально состояние своего здоровья. Онкология и аутоиммунки «хорошо» стимулируются интерферонами
Человек может болеть по 3,4 и 7 даже раз в год орви без осложнений, и это нормально. Каждый раз использовать недоказанное по эффективности вещество - деньги на ветер. Зачем лезть в иммунная систему? Вы же не знаете досконально состояние своего здоровья. Онкология и аутоиммунки «хорошо» стимулируются интерферонами
Спасибо. Есть над чем подумать. Осложнения и улучшения отпишу
2020 October 26
ГР
Цитовир-3 эффективное ли лекарство для ребёнка трёх лет?
Y
Переслано от Расстрельный Список...
Цитовир-3 (Cytovir-3/аскорбинка + тимоген (см. выше) + бендазол (см. выше)) — иммуномодулятор и индуктор интерферона для терапии всех инфекций. Самый новый, представляющийся как исключительно нечто, лучше всего вышеупомянутого (на офф сайте перечислены «недостатки» арбидола, кагоцела и проч., которые (якобы) отсутствуют в данном снадобье). Никаких обоснований, ни фармакодинамики, ни механизма действия, исследований эффективности нет. Pubmed 0; Cochrane Reviews 0; FDA 0; RXlist 0; ВОЗ 0; ФК (-).
AK
здравствуйте, подскажите пожалуйста, аквалор вызывает привыкание, спасибо
Аквалор это просто соленая вода
NK
NK
Честно, не совсем понимаю, что так сильно удивило людей? Если бы такое количество мешком было на улице, возле больнице – это да, страшно. Мешки с телами в морге – а где им ещё быть? Практически любой умерший человек отправляется туда, иначе как понять, умер человек сам или ему помогли.
Когда я работал в больнице, ещё в доковидную эпоху – в морге и тогда было много трупов. А в 2010 году, когда была аномальная жара и пожилые люди по больничной статистике умирали в 3-4 раза чаще – может и больше. Единственное отличие – теперь тела хранятся в мешках. Я застал ещё времена, когда никаких мешков не было и всё это выглядело в десятки раз криповее. Если вы хоть раз бывали в морге – понимаете о чём я.
Сейчас у нас истерия по поводу COVID-19, поэтому скорее всего, даже в тех случаях, когда смерть от естественных причин не вызывает сомнений, они будут отправляться в морг. Раньше, если человек, предположим, умер от терминальной стадии рака – вскрытие можно было не проводить, но тоже не всегда.
Стало ли умерших в морге больше с прошлого года – автор не сказал. Какой это день недели? Выходные, когда трупы не вскрывают и они просто складируются? Или может у них всегда столько. Я не ставлю под сомнение возможность ситуации, когда тел реально много я просто не сильно в последнее время доверяю видеороликами из интернета и сообщениям из воцап-чатов.
Сейчас можно выложить практически любой ролик на котором есть что-то связанное с ковидом и закадровым голосом в стиле “посмотрите какой ужас” и всё: люди повсеместно начинают это обсуждать в том ключе, в котором предлагает автор, даже не задаваясь вопросом, а правда ли то, что на видео.
А когда становится ясно, что это всё полная дичь – большинство уже благополучно забыли и обсуждают что-нибудь новое.
Конкретно в случае с моргом и мешками с трупами – такое уже было, и не раз, и не только у нас. Если помните, то в начале пандемии по интернету бродил ролик якобы из Нью-Йорка, где якобы начался тотальный звездец. На видео были чёрные мешки, прямо посреди улицы, а оператор выкрикивал комментарии, типа “Ааа, мы все умрём!”. Вот это хайп был. Люди прекрасно приняли данную новость и стали делиться ей друг с другом, ещё больше нагнетая массовую истерию. А когда стало ясно, что это галимый фейк и тела просто перекладывали из одного сломанного рефрижератора в другой – всем уже было плевать.
Я не думаю, что автор видео из Новокузнецкой больницы преследовал цель кого-то напугать или похайпиться, и скорее всего тел сейчас в моргах больше чем обычно. Но это далеко не всегда связано с тем, что выросла смертность. Скорее с трудностями при вскрытии – потому что если есть даже малейшее ПОДОЗРЕНИЕ на COVID-19 (т.е. почти всегда) – автоматически подключает множество бюрократических проволочек, из-за которых тела пребывают в морге дольше, чем нужно.
"Тела лежат на полу?! Какой ужас!" – К умершим в больницах во всё мире относятся без лишней сентиментальности. Печально, но так устроен мир. Мне бы тоже хотелось чтобы тела хранились как голливудских фильмах: в кристально чистых подвалах, с аккуратными выдвигающимися рефрижераторами. Но реальность такова, что такие холодильники, в массе своей – только в фильмах и есть.
Что в сухом остатке: на видео я увидел морг и много черных мешков с телами.
Неприятно? – Да. Является ли это сенсацией и доказательством того, что “ВСЕ ПРОПАЛО, МЫ ВСЕ УМРЁМ!”? – Нет.
Плохо ли, что тела близких кому-то людей так храняться? Плохо, но с этой реальностью придётся жить.
Стоит ли переживать из-за этого ролика? – Конечно нет.
Стоит ли пожилым людям лишний раз не выходить из дома без нужды? – Да стоит. А молодым, если вы живете с пожилыми – старайтесь с ними не контактировать просто так, дабы не заразить. Потому что пожилые – это те люди, которым в первую очередь нужно боятся коронавируса.
Когда я работал в больнице, ещё в доковидную эпоху – в морге и тогда было много трупов. А в 2010 году, когда была аномальная жара и пожилые люди по больничной статистике умирали в 3-4 раза чаще – может и больше. Единственное отличие – теперь тела хранятся в мешках. Я застал ещё времена, когда никаких мешков не было и всё это выглядело в десятки раз криповее. Если вы хоть раз бывали в морге – понимаете о чём я.
Сейчас у нас истерия по поводу COVID-19, поэтому скорее всего, даже в тех случаях, когда смерть от естественных причин не вызывает сомнений, они будут отправляться в морг. Раньше, если человек, предположим, умер от терминальной стадии рака – вскрытие можно было не проводить, но тоже не всегда.
Стало ли умерших в морге больше с прошлого года – автор не сказал. Какой это день недели? Выходные, когда трупы не вскрывают и они просто складируются? Или может у них всегда столько. Я не ставлю под сомнение возможность ситуации, когда тел реально много я просто не сильно в последнее время доверяю видеороликами из интернета и сообщениям из воцап-чатов.
Сейчас можно выложить практически любой ролик на котором есть что-то связанное с ковидом и закадровым голосом в стиле “посмотрите какой ужас” и всё: люди повсеместно начинают это обсуждать в том ключе, в котором предлагает автор, даже не задаваясь вопросом, а правда ли то, что на видео.
А когда становится ясно, что это всё полная дичь – большинство уже благополучно забыли и обсуждают что-нибудь новое.
Конкретно в случае с моргом и мешками с трупами – такое уже было, и не раз, и не только у нас. Если помните, то в начале пандемии по интернету бродил ролик якобы из Нью-Йорка, где якобы начался тотальный звездец. На видео были чёрные мешки, прямо посреди улицы, а оператор выкрикивал комментарии, типа “Ааа, мы все умрём!”. Вот это хайп был. Люди прекрасно приняли данную новость и стали делиться ей друг с другом, ещё больше нагнетая массовую истерию. А когда стало ясно, что это галимый фейк и тела просто перекладывали из одного сломанного рефрижератора в другой – всем уже было плевать.
Я не думаю, что автор видео из Новокузнецкой больницы преследовал цель кого-то напугать или похайпиться, и скорее всего тел сейчас в моргах больше чем обычно. Но это далеко не всегда связано с тем, что выросла смертность. Скорее с трудностями при вскрытии – потому что если есть даже малейшее ПОДОЗРЕНИЕ на COVID-19 (т.е. почти всегда) – автоматически подключает множество бюрократических проволочек, из-за которых тела пребывают в морге дольше, чем нужно.
"Тела лежат на полу?! Какой ужас!" – К умершим в больницах во всё мире относятся без лишней сентиментальности. Печально, но так устроен мир. Мне бы тоже хотелось чтобы тела хранились как голливудских фильмах: в кристально чистых подвалах, с аккуратными выдвигающимися рефрижераторами. Но реальность такова, что такие холодильники, в массе своей – только в фильмах и есть.
Что в сухом остатке: на видео я увидел морг и много черных мешков с телами.
Неприятно? – Да. Является ли это сенсацией и доказательством того, что “ВСЕ ПРОПАЛО, МЫ ВСЕ УМРЁМ!”? – Нет.
Плохо ли, что тела близких кому-то людей так храняться? Плохо, но с этой реальностью придётся жить.
Стоит ли переживать из-за этого ролика? – Конечно нет.
Стоит ли пожилым людям лишний раз не выходить из дома без нужды? – Да стоит. А молодым, если вы живете с пожилыми – старайтесь с ними не контактировать просто так, дабы не заразить. Потому что пожилые – это те люди, которым в первую очередь нужно боятся коронавируса.
ДХ
ID:0
Вчера пришел десяток вопросов с просьбой прокомментировать историю с моргом в Новокузнецке.
Я не истина в последний инстанции, и понимаю, что моё мнение может быть в меньшинстве, но я его выскажу.
Я не истина в последний инстанции, и понимаю, что моё мнение может быть в меньшинстве, но я его выскажу.
Согласна с вашим высказыванием.и кстати может это единственный морг на весь город или туда свозят трупы с близлежащих поселков,любят у нас люди нагнетать